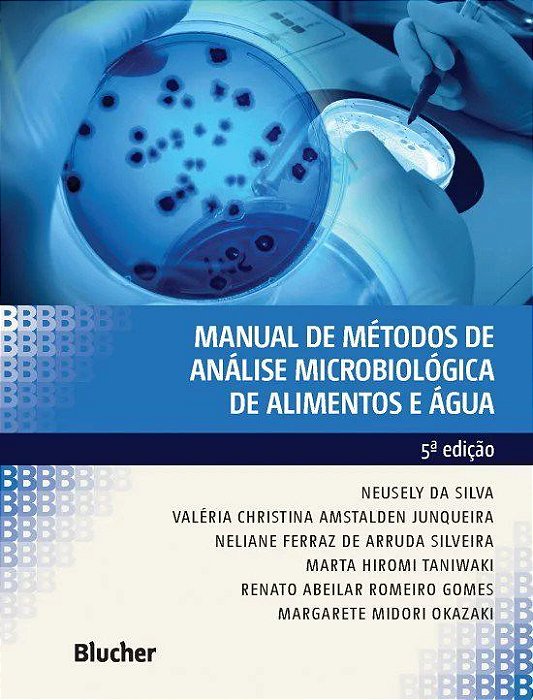
Livro Manual de Metodos de Analise Microbiologica de Alimentos e Agua - Silva/junqueira/silv

Livro Manual de Metodos de Analise Microbiologica de Alimentos e Agua - Silva/junqueira/silv
R$ 308,00
até
12x
de
R$ 25,66
sem juros
ou R$ 292,60
via Boleto Bancário
Comprar
Estoque:
Disponível
-
- 1x de R$ 308,00 sem juros
- 2x de R$ 154,00 sem juros
- 3x de R$ 102,66 sem juros
- 4x de R$ 77,00 sem juros
- 5x de R$ 61,60 sem juros
- 6x de R$ 51,33 sem juros
- 7x de R$ 44,00 sem juros
- 8x de R$ 38,50 sem juros
- 9x de R$ 34,22 sem juros
- 10x de R$ 30,80 sem juros
- 11x de R$ 28,00 sem juros
- 12x de R$ 25,66 sem juros
-
- 1x de R$ 308,00 sem juros
- 2x de R$ 168,85
- 3x de R$ 114,20
- 4x de R$ 85,75
- 5x de R$ 70,41
- 6x de R$ 58,68
- 7x de R$ 51,36
- 8x de R$ 44,94
- 9x de R$ 40,96
- 10x de R$ 37,16
- 11x de R$ 33,78
- 12x de R$ 31,34
-
R$ 292,60

ISBN 9788521212256
Edição 5
Ano 2017
Idioma Português
Autor Silva/junqueira/silv
Páginas 535
Encadernação Brochura
Disponibilidade Entrega Imediata para 01 unidade
Sinopse:
Não Disponível.
Produtos relacionados
-
 Livro Manual de Métodos de Análise Microbiológica de Alimentos e ÁguaR$ 297,00até 12x de R$ 24,75 sem jurosou R$ 282,15 via Boleto Bancário
Livro Manual de Métodos de Análise Microbiológica de Alimentos e ÁguaR$ 297,00até 12x de R$ 24,75 sem jurosou R$ 282,15 via Boleto Bancário -
 Livro Microbiologia dos Alimentos FrancoR$ 188,00até 9x de R$ 20,88 sem jurosou R$ 178,60 via Boleto Bancário
Livro Microbiologia dos Alimentos FrancoR$ 188,00até 9x de R$ 20,88 sem jurosou R$ 178,60 via Boleto Bancário -
 Livro Sos Plantao - Emergencias Medicas da Crianca ao Idoso - Junqueira Filho/silvR$ 315,00até 12x de R$ 26,25 sem jurosou R$ 299,25 via Boleto Bancário
Livro Sos Plantao - Emergencias Medicas da Crianca ao Idoso - Junqueira Filho/silvR$ 315,00até 12x de R$ 26,25 sem jurosou R$ 299,25 via Boleto Bancário -
 Livro Consultoria por Analise de Balancos - SilvaR$ 176,88até 8x de R$ 22,11 sem jurosou R$ 168,04 via Boleto Bancário
Livro Consultoria por Analise de Balancos - SilvaR$ 176,88até 8x de R$ 22,11 sem jurosou R$ 168,04 via Boleto Bancário
-
Categorias
Conteúdo
Sobre a loja
A Livro Pro é uma livraria especializada em livros técnicos e didáticos, com atuação focada nas áreas da saúde, direito, ciências humanas e ciências exatas. Nosso catálogo é cuidadosamente selecionado para atender às necessidades de estudantes, professores, pesquisadores e profissionais, oferecendo obras atualizadas, reconhecidas academicamente e alinhadas às exigências do mercado e da formação educacional. Trabalhamos com conteúdos que apoiam a graduação e pós-graduação até a atualização profissional!
Contato
Pague com
Selos